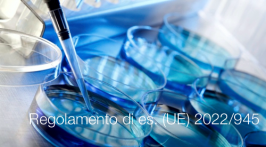
Regolamento di esecuzione (UE) 2022/945

Regolamento di esecuzione (UE) 2022/1107

Regolamento di esecuzione (UE) 2022/1107
Regolamento di esecuzione (UE) 2022/1107 della Commissione del 4 luglio 2022 che stabilisce specifiche comuni per alcuni dispositivi medico-diagnostici in vitro della classe D conformemente al regolamento…
Leggi tutto Regolamento di esecuzione (UE) 2022/1107Regolamento delegato (UE) 2022/973

Regolamento delegato (UE) 2022/973
Regolamento delegato (UE) 2022/973 della Commissione del 14 marzo 2022 che integra il regolamento (UE) 2019/1009del Parlamento europeo e del Consiglio stabilendo criteri in materia di efficienza agronomica…
Leggi tutto Regolamento delegato (UE) 2022/973Regolamento di esecuzione (UE) 2022/944

Regolamento di esecuzione (UE) 2022/944
Regolamento di esecuzione (UE) 2022/944 della Commissione del 17 giugno 2022 recante modalità di applicazione del regolamento (UE) 2017/746del Parlamento europeo e del Consiglio per quanto riguarda…
Leggi tutto Regolamento di esecuzione (UE) 2022/944Direttiva 91/368/CEE

Direttiva 91/368/CEE
Direttiva 91/368/CEE del Consiglio, del 20 giugno 1991, che modifica la direttiva 89/392/CEE concernente il ravvicinamento delle legislazioni degli Stati membri relative alle macchine
(GU L 198 del 22.7.1991)
Abrogata da: Direttiva 98/37/CE
Documento timeline evoluzione del testo della Direttiva macchine
Collegati
Rettifica del regolamento (UE) 2015/1185 | 16.06.2022
Rettifica del regolamento (UE) 2015/1185 | 16.06.2022
Rettifica del regolamento (UE) 2015/1185 della Commissione, del 24 aprile 2015, recante modalità di applicazione della direttiva 2009/125/CE del Parlamento europeo e del Consiglio in merito…
Leggi tutto Rettifica del regolamento (UE) 2015/1185 | 16.06.2022EMC Prodotti | Direttiva 2014/30/UE e NTA

EMC Prodotti | Direttiva 2014/30/UE e NTA / Ed. 6.0 Giugno 2022
Regolamento macchine: il Consiglio adotta un mandato per i negoziati con il Parlamento
Regolamento di esecuzione (UE) 2022/945
Regolamento di esecuzione (UE) 2022/945
Regolamento di esecuzione (UE) 2022/945 della Commissione del 17 giugno 2022 recante modalità di applicazione del regolamento (UE) 2017/746 del Parlamento europeo e del Consiglio per…
Leggi tutto Regolamento di esecuzione (UE) 2022/945Direttiva 93/44/CEE

Direttiva 93/44/CEE
Direttiva 93/44/CEE del Consiglio del 14 giugno 1993 che modifica la direttiva 89/392/CEE concernente il ravvicinamento delle legislazioni degli Stati Membri relative alle macchine
(GU L 175 del 19.7.1993)
Abrogata da: Direttiva 98/37/CE
Documento timeline evoluzione del testo della Direttiva macchine
Collegati
Direttiva 89/392/CEE

Direttiva 89/392/CEE / 1a Direttiva macchine
Direttiva 89/392/CEE del Consiglio, del 14 giugno 1989, concernente il ravvicinamento delle legislazioni degli Stati Membri relative alle macchine.
(GU L 183 del 29.6.1989)
Abrogata da: Direttiva 98/37/CE
Documento timeline evoluzione del testo della Direttiva macchine
Collegati
Rettifica del regolamento (UE) 2019/1009 | 16.06.2022
Rettifica del regolamento (UE) 2019/1009 | 16.06.2022
Rettifica del regolamento (UE) 2019/1009del Parlamento europeo e del Consiglio, del 5 giugno 2019, che stabilisce norme relative alla messa a disposizione sul…
Leggi tutto Rettifica del regolamento (UE) 2019/1009 | 16.06.2022Decreto 26 aprile 2022

Decreto 26 aprile 2022
Modalita' e criteri di svolgimento della vigilanza sul mercato e il controllo sui prodotti del diporto.
(GU n.130 del 06.06.2022)
...
Art. 1. Finalità e…
Leggi tutto Decreto 26 aprile 2022Altri articoli...
- Decreto Ministeriale 1° dicembre 1975
- Proposal for the General Product Safety Regulation (GPSR)
- Supporting Study for the evaluation of NLF | 04.05.2022
- DPR 6 ottobre 1999 n. 407
- D.P.R. 20 dicembre 2017 n. 239 | Equipaggiamento marittimo
- Direttiva 2014/90/UE e Direttiva 2014/93/UE Equipaggiamento marittimo
- Decreto 31 marzo 2022
- Decreto Ministeriale 19 luglio 1989
- Regolamento delegato (UE) 2022/518
- Direttiva 94/1/CE







































